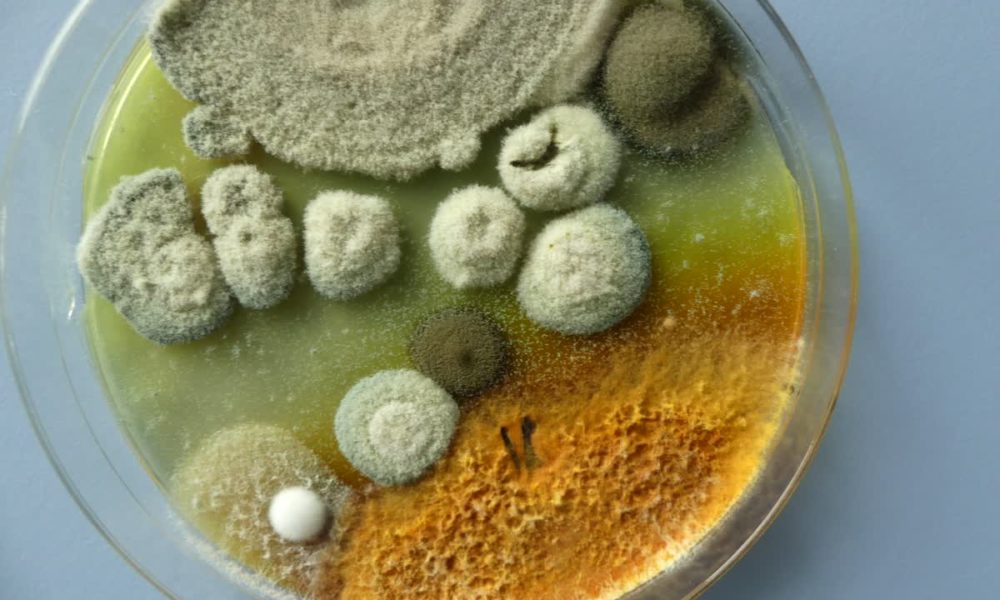
pleśń w powietrzu

Tag: wpływ grzybów pleśniowych na zdrowie człowieka
Grzyby pleśniowe w powietrzu – czym są i skąd się biorą?
Grzyby pleśniowe to mikroorganizmy powszechnie występujące w środowisku naturalnym. W powietrzu obecne są głównie w postaci zarodników, czyli struktur umożliwiających im rozmnażanie i rozprzestrzenianie się. Zarodniki te są niewidoczne gołym okiem, bardzo lekkie i łatwo unoszą się w powietrzu, dostając się do wnętrz budynków przez okna, drzwi oraz systemy wentylacyjne.
W środowisku wewnętrznym grzyby pleśniowe mogą rozwijać się na różnych powierzchniach, zwłaszcza tam, gdzie występuje podwyższona wilgotność. Do najczęstszych źródeł należą zawilgocone ściany i sufity, nieszczelne instalacje wodno-kanalizacyjne, mostki termiczne, materiały budowlane, dywany, tapicerka oraz kurz domowy. Sprzyjające warunki do ich wzrostu to wilgotność powietrza przekraczająca 60% oraz ograniczona wymiana powietrza.
Występowanie niewielkiej ilości zarodników grzybów pleśniowych w powietrzu jest zjawiskiem naturalnym. Problem pojawia się wówczas, gdy ich stężenie znacząco wzrasta, co może świadczyć o nieprawidłowych warunkach mikroklimatycznych w budynku i prowadzić do negatywnych konsekwencji zdrowotnych oraz technicznych.
Jak grzyby pleśniowe wpływają na zdrowie człowieka?
Grzyby pleśniowe mogą oddziaływać na zdrowie człowieka alergizująco, toksycznie, zakaźnie lub rakotwórczo.
Zarodniki grzybów są integralnym składnikiem powietrza w środowisku pracy i w budynkach mieszkalnych. Przenoszone są z prądami powietrza, z ruchem ludzi i zwierząt, a w pomieszczeniach zamkniętych rozprzestrzeniają się pod wpływem wentylacji. Szacuje się, że dorosły człowiek wykonuje od 20 do 22 tys. oddechów w ciągu doby, wymieniając od 10 – 20 m3 powietrza ze wszystkimi zanieczyszczeniami, które się w nim znajdują.